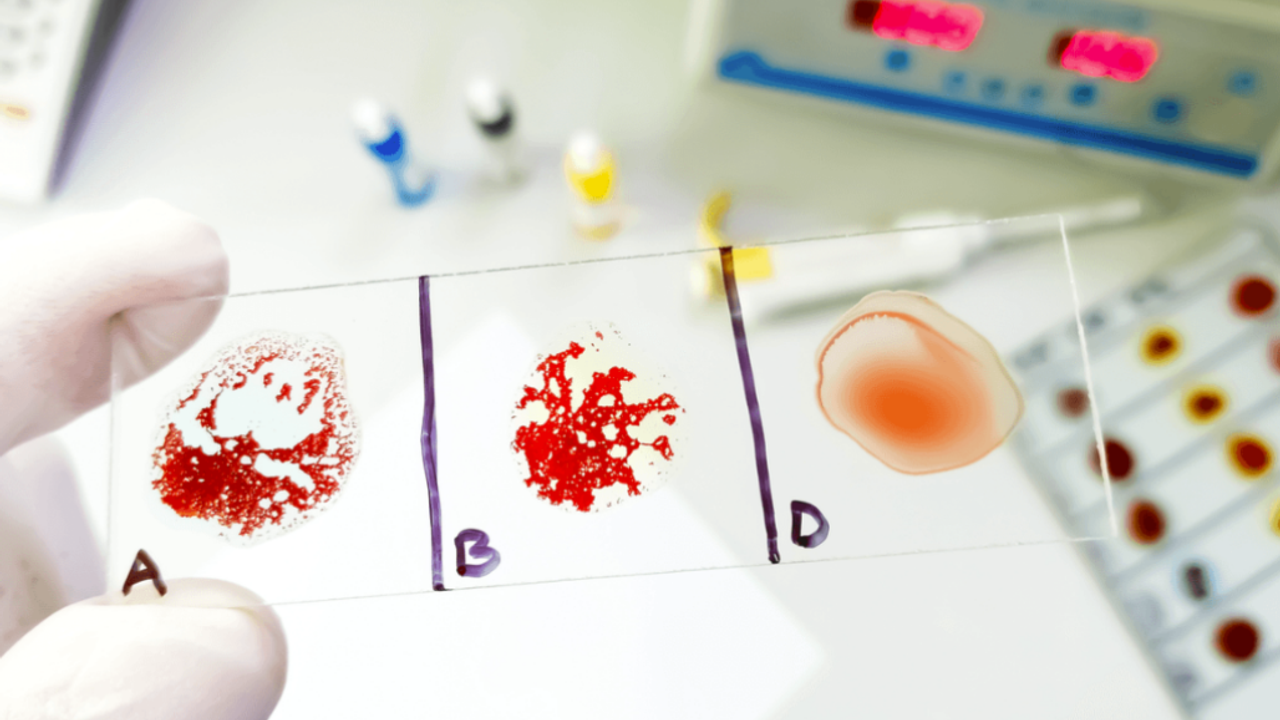

Rusya’daki Baltık Federal Üniversitesi (BFU) bilim insanları, insan trombositleri (kan pulcukları) üzerinde yapılan testlerin en ideal zaman aralığının, kan alındıktan sonra 2 ila 4 saat arasında olduğunu açıkladı. Bu bulgu, Raman saçılma spektroskopisi adı verilen bir analiz tekniği kullanılarak elde edildi.
Araştırmacılar, trombositlerin damar hasarı durumunda kanamayı durdurmak için pıhtılaşma oluşturan kan hücreleri olduğunu ve bu hücrelerin sayısının fazla olması durumunda kalp krizi veya inme riskinin arttığını, yetersiz olması durumunda ise kanamaya yol açtığını vurguladı.
Raman saçılma spektroskopisi, trombositlerin biyokimyasal yapısı hakkında bilgi sağlar ve hücrelerdeki erken yapısal değişiklikleri tespit etmeye olanak tanır.
Kan, insan vücudunun yaklaşık %7-8’ini oluşturan sıvı bir dokudur ve kalp tarafından vücudun her noktasına pompalanır. Bu sistem, bir şehri ayakta tutan entegre ulaşım ağına benzetilebilir. Oksijeni akciğerlerden hücrelere, besinleri sindirim sisteminden dokulara taşır. Geri dönüş yolunda ise karbondioksit ve atık maddeleri toplar ve vücuttan atılmalarını sağlar. Bu sistem olmadan yaşam sürdürülemez.
BFU’daki “Temel ve Uygulamalı Fotonik, Nano Fotonik” Araştırma Merkezi’nden araştırmacı Elizaveta Demişkeviç, günümüzde pek çok bilim insanının bu optik yöntemi kalp-damar hastalıklarını incelemek için kullandığını söyledi.
Demişkeviç, bu yöntemin oldukça yaygın ve umut verici olduğunu, araştırmacıların bu teknik üzerinde sürekli iyileştirmeler yaptığını, ancak her zaman biyolojik sıvılarla, özellikle trombosit açısından zengin plazma ile çalışıldığını belirtti.
Ayrıca, bu hücrelerin çevresel etmenlere duyarlı ve karmaşık yapılar olduğunu vurgulayarak, güvenilir sonuçlar elde edebilmek için orijinal moleküler yapıların korunmasının büyük önem taşıdığını ifade etti.
Demişkeviç, “Kan hücrelerinin 4°C’de saklandığı koşullarda, güvenilir deney sonuçları için en uygun zaman aralığının 2 ila 4 saat olduğunu kanıtladık,” dedi. Bu süreden sonra trombositlerde yapısal bozulmalar başladığını ve işlevlerinin azaldığını söyledi.
Rus bilim insanları, elde edilen sonuçların trombosit açısından zengin plazmayı kullanan ticari laboratuvarlar ve estetik klinikler için de yararlı olabileceğini belirtti. Özellikle PRP (Platelet-Rich Plasma) ile yüz gençleştirme uygulamalarının popüler hale geldiği günümüzde, bu yöntem hastanın kendi plazmasının yeniden yapılandırıcı süreçleri teşvik etmek amacıyla cilde enjekte edilmesini içeriyor.